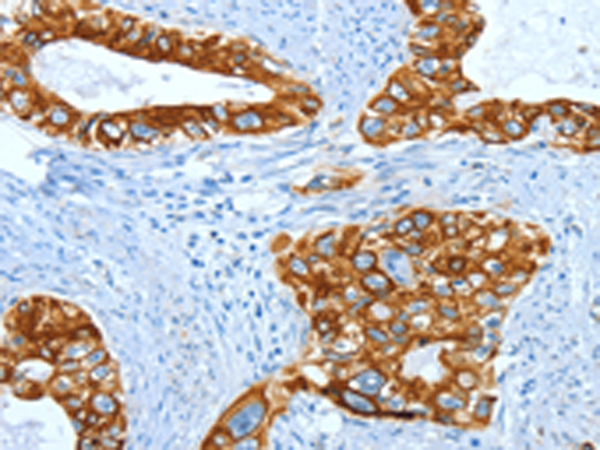

相關(guān)類別: 一抗
反應(yīng)種屬: Human, Mouse, Rat
Background:
This gene encodes a member of the type I (acidic) keratin family, which belongs to the superfamily of intermediate filament (IF) proteins. Keratins are heteropolymeric structural proteins which form the intermediate filament. These filaments, along with actin microfilaments and microtubules, compose the cytoskeleton of epithelial cells. The type I keratin genes are clustered in a region of chromosome 17q12-q21.
Applications:
ELISA, WB, IHC
Name of antibody:
KRT40
Immunogen:
Fusion protein of human KRT40
Full name:
keratin 40
Synonyms:
K40; KA36; CK-40
SwissProt:
Q6A162
ELISA Recommended dilution:
2000-5000
IHC positive control:
Human cervical cancer and human thyroid cancer
IHC Recommend dilution:
50-200
WB Predicted band size:
48 kDa
WB Positive control:
Lovo cells
WB Recommended dilution:
500-2000
技術(shù)規(guī)格

購物車
購物車 幫助
幫助
 021-54845833/15800441009
021-54845833/15800441009
